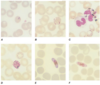
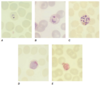

Leptospires have this type of flagella
2 periplasmic flagella
Most impt reservoir of leptospires
rodents
T/F
The vast majority of infections with Leptospira cause no or only mild disease in humans.
True
T/F
During the immune phase, the appearance of antibodies coincides with the disappearance of leptospires from the blood.
True
However, the bacteria persist in various organs, including liver, lung, kidney, heart, and brain
During the immune phase, resolution of symptoms may coincide with the appearance of antibodies, and leptospires can be cultured from the urine
Usual incubation period of leptospirosis
2-30
The incubation period is usually 1–2 weeks but ranges from 2 to 30 days.

2 phases of leptospirosis
The acute leptospiremic phase is characterized by fever of 3–10 days’ duration, during which time the organism can be cultured from blood and detected by (PCR).
During the immune phase, resolution of symptoms may coincide with the appearance of antibodies, and leptospires can be cultured from the urine.

Weil’s syndrome triad
Weil’s syndrome, encompasses the triad of hemorrhage, jaundice, and acute kidney injury.
Typical electrolyte abnormality in leptospirosis
Typical electrolyte abnormalities include hypokalemia and hyponatremia
Common ECG finding in leptospirosis
Cardiac involvement is commonly reflected on the electrocardiogram as nonspecific ST- and T-wave changes. Repolarization abnormalities and arrhythmias are considered poor prognostic factors
Most common radiologic finding in severe leptospirosis
The most common radiographic finding is a patchy bilateral alveolar pattern that corresponds to scattered alveolar hemorrhage.
Based on Harrisons , how is leptospirosis confirmed
A definitive diagnosis of leptospirosis is based on isolation of the organism from the patient, on a positive result in the PCR, or on seroconversion or a rise in antibody titer.
In cases with strong clinical evidence of infection, a single antibody titer of 1:200–1:800 (depending on whether the case occurs in a low- or high-endemic area) in the microscopic agglutination test (MAT) is required.
** In CPG At least 1:1600 is enough for diagnosis
Preferably, a fourfold or greater rise in titer is detected between acute- and convalescent-phase serum specimens.
In rare instances, a ______ reaction
develops within hours after the initiation of antimicrobial therapy for leptospirosis
Jarisch-Herxheimer
Treatment for leptospirosis

Based on CPG when do you suspect leptospirosis?

Based on CPG what are the lab results that may indicate severe leptospirosis?

Based on CPG what are the recommended tests for AKI in leptospirosis?

Based on CPG what is the IVF of choice for px with leptospirosis presenting with shock?
Plain NSS with K incorporation
Based on CPG, what are the indications for HD for leptospirosis
Almost same values as severe lepto but K should be > 5
HD should be done DAILY in critically ill px

Based on CPG how do you manage oliguria in leptospirosis

Based on CPG, what is the 1st sign of pulmonary involvement in leptospirosis?
tachypnea >30
Based on CPG, what are the 2 most common pulmonary complications of leptospirosis?
Pulmonary hemorrhage and ARDS
Based on CPG, how do you treat the pulmonary complications of leptospirosis?
Methylprednisolone should be given as 1gm IV for 3 days then should be continued as oral prednisolone 1mg/kg/day for 7 more days

Based on CPG, recommended PRE exposure prophy for leptospirosis

Based on CPG, duration of POST exposure prophylaxis for leptospirosis